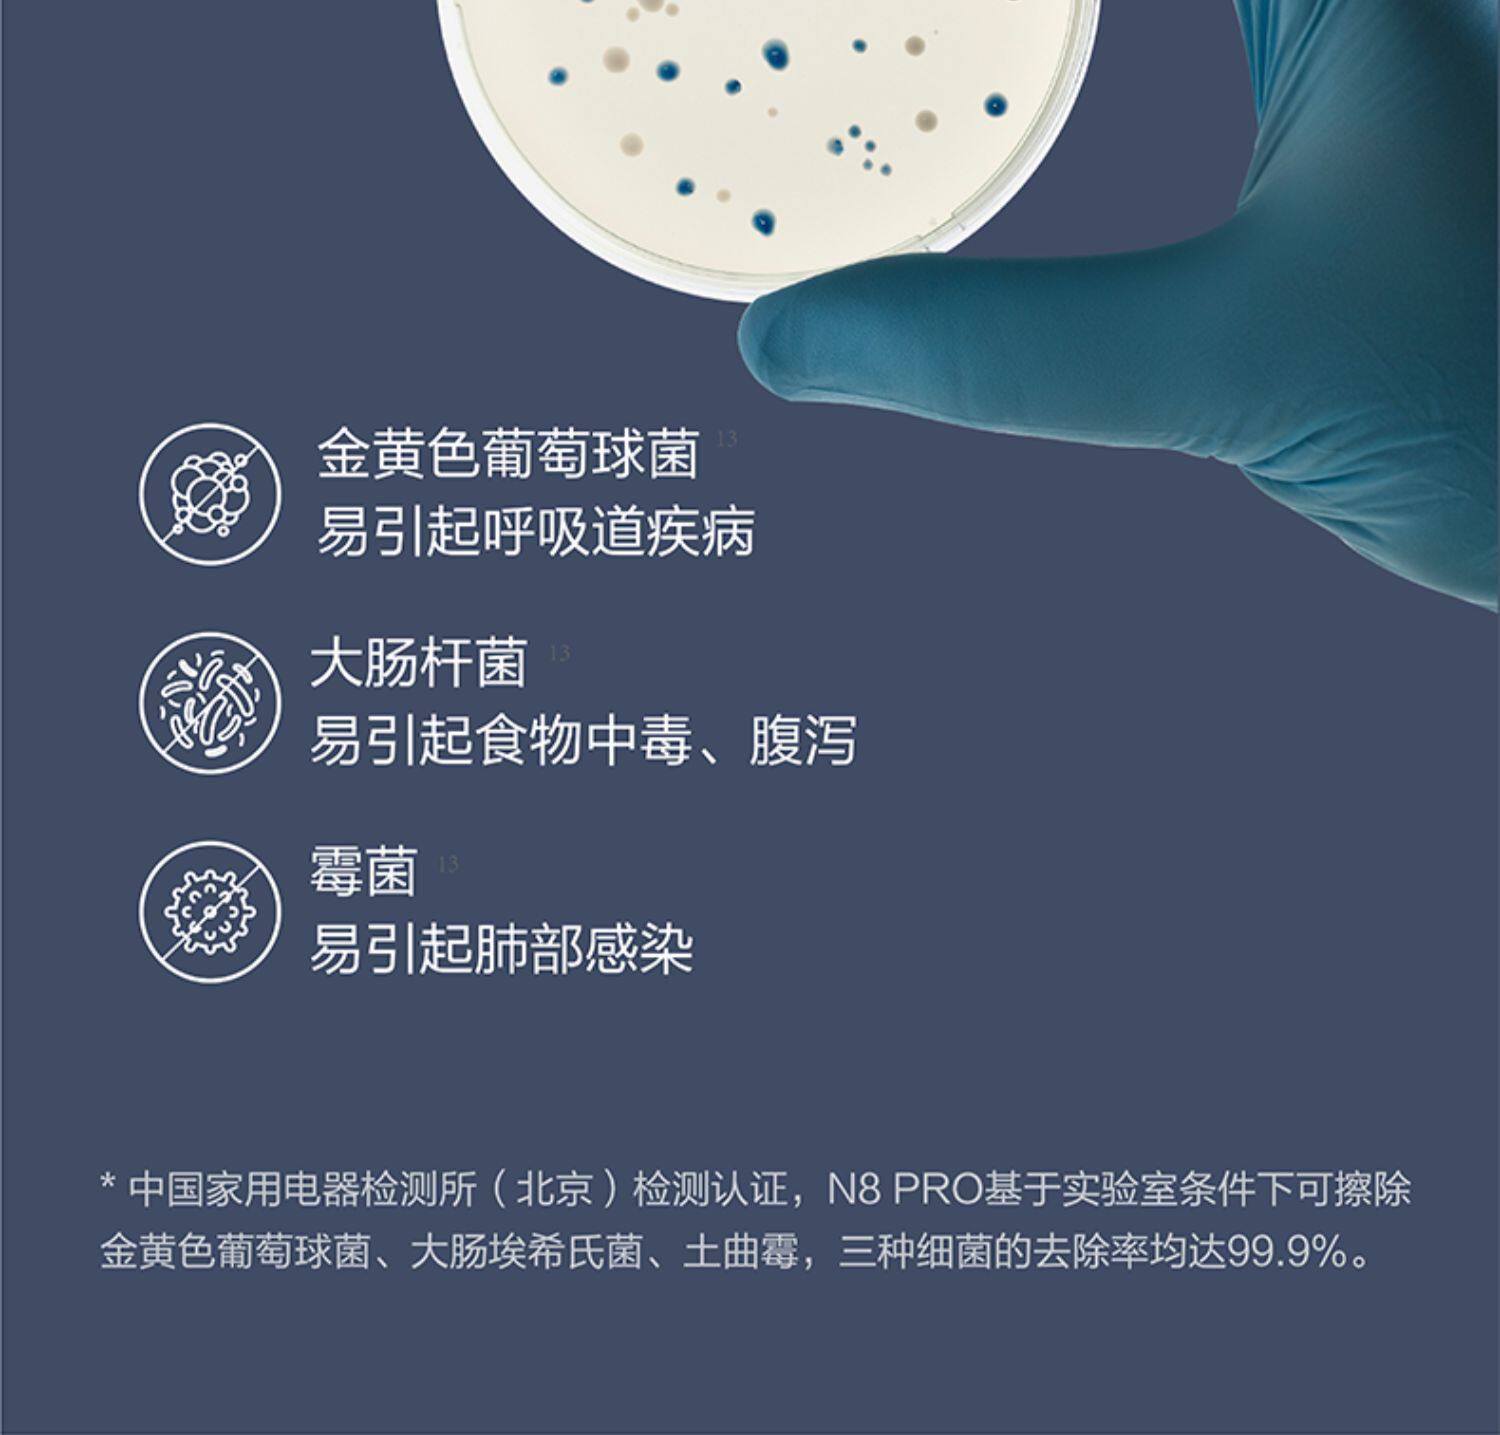

- Таобао
- Техника
- Бытовая техника
- Электрические щетки для уборки
- 655127247203
Ecovacs N8PRO подметальный робот для умного дома, полностью автоматическая подметание, стерилизация, подметание и мытье полов три в одном

Цена: 54 138руб. (¥2599)
Артикул: 655127247203
Вес товара: ~0.7 кг. Указан усредненный вес, который может отличаться от фактического. Не включен в цену, оплачивается при получении.
Описание товараPGRpdj48aW1nIHNyYz0iaHR0cHM6Ly9pbWcuYWxpY2RuLmNvbS9pbWdleHRyYS9pNC8yNjM3MjYyODYvTzFDTjAxVWFqMlpUMXdKMlB0MlBtTE9fISEyNjM3MjYyODYuanBnIj48L2Rpdj48ZGl2PjxpbWcgc3JjPSJodHRwczovL2ltZy5hbGljZG4uY29tL2ltZ2V4dHJhL2kyLzI2MzcyNjI4Ni9PMUNOMDE0UlB6QmIxd0oyUTFtS0RXUl8hITI2MzcyNjI4Ni5qcGciPjwvZGl2PjxkaXY+PGltZyBzcmM9Imh0dHBzOi8vaW1nLmFsaWNkbi5jb20vaW1nZXh0cmEvaTQvMjYzNzI2Mjg2L08xQ04wMU1HelRMSTF3SjJQdlN0cW1RXyEhMjYzNzI2Mjg2LmpwZyI+PC9kaXY+PGRpdj48aW1nIHNyYz0iaHR0cHM6Ly9pbWcuYWxpY2RuLmNvbS9pbWdleHRyYS9pMi8yNjM3MjYyODYvTzFDTjAxTVJkWnQzMXdKMlB2TDFxbTdfISEyNjM3MjYyODYuanBnIj48L2Rpdj48ZGl2PjxpbWcgc3JjPSJodHRwczovL2ltZy5hbGljZG4uY29tL2ltZ2V4dHJhL2kxLzI2MzcyNjI4Ni9PMUNOMDFvelFKSnkxd0oyUFVMRlFEZl8hITI2MzcyNjI4Ni5qcGciPjwvZGl2PjxkaXY+PGltZyBzcmM9Imh0dHBzOi8vaW1nLmFsaWNkbi5jb20vaW1nZXh0cmEvaTIvMjYzNzI2Mjg2L08xQ04wMUxkUjhmaDF3SjJQUno5SkxjXyEhMjYzNzI2Mjg2LmpwZyI+PC9kaXY+PGRpdj48aW1nIHNyYz0iaHR0cHM6Ly9pbWcuYWxpY2RuLmNvbS9pbWdleHRyYS9pNC8yNjM3MjYyODYvTzFDTjAxc0JvR0o1MXdKMlBhVkZteUpfISEyNjM3MjYyODYuanBnIj48L2Rpdj48ZGl2PjxpbWcgc3JjPSJodHRwczovL2ltZy5hbGljZG4uY29tL2ltZ2V4dHJhL2kxLzI2MzcyNjI4Ni9PMUNOMDFBR1BTQXExd0oyUGJEVUFCYl8hITI2MzcyNjI4Ni5qcGciPjwvZGl2PjxkaXY+PGltZyBzcmM9Imh0dHBzOi8vaW1nLmFsaWNkbi5jb20vaW1nZXh0cmEvaTEvMjYzNzI2Mjg2L08xQ04wMTdNakhvWTF3SjJQVUF0c2x6XyEhMjYzNzI2Mjg2LmpwZyI+PC9kaXY+PGRpdj48aW1nIHNyYz0iaHR0cHM6Ly9pbWcuYWxpY2RuLmNvbS9pbWdleHRyYS9pNC8yNjM3MjYyODYvTzFDTjAxTGp3ZnQyMXdKMlBZYVQ4aWlfISEyNjM3MjYyODYuanBnIj48L2Rpdj48ZGl2PjxpbWcgc3JjPSJodHRwczovL2ltZy5hbGljZG4uY29tL2ltZ2V4dHJhL2kxLzI2MzcyNjI4Ni9PMUNOMDE5aENKUEExd0oyUGFWRldMOF8hITI2MzcyNjI4Ni5qcGciPjwvZGl2PjxkaXY+PGltZyBzcmM9Imh0dHBzOi8vaW1nLmFsaWNkbi5jb20vaW1nZXh0cmEvaTMvMjYzNzI2Mjg2L08xQ04wMWxzMDhCQzF3SjJQVUxDYmRCXyEhMjYzNzI2Mjg2LmpwZyI+PC9kaXY+PGRpdj48aW1nIHNyYz0iaHR0cHM6Ly9pbWcuYWxpY2RuLmNvbS9pbWdleHRyYS9pMi8yNjM3MjYyODYvTzFDTjAxbmZzbllTMXdKMlBaSHZScnVfISEyNjM3MjYyODYuanBnIj48L2Rpdj48ZGl2PjxpbWcgc3JjPSJodHRwczovL2ltZy5hbGljZG4uY29tL2ltZ2V4dHJhL2k0LzI2MzcyNjI4Ni9PMUNOMDFXREZSb2Exd0oyUFVMRUxnal8hITI2MzcyNjI4Ni5qcGciPjwvZGl2PjxkaXY+PGltZyBzcmM9Imh0dHBzOi8vaW1nLmFsaWNkbi5jb20vaW1nZXh0cmEvaTMvMjYzNzI2Mjg2L08xQ04wMUVTNWtIUDF3SjJQVjBHSEkxXyEhMjYzNzI2Mjg2LmpwZyI+PC9kaXY+PGRpdj48aW1nIHNyYz0iaHR0cHM6Ly9pbWcuYWxpY2RuLmNvbS9pbWdleHRyYS9pMy8yNjM3MjYyODYvTzFDTjAxd1JyQWhpMXdKMlBjTWFrUlVfISEyNjM3MjYyODYuanBnIj48L2Rpdj48ZGl2PjxpbWcgc3JjPSJodHRwczovL2ltZy5hbGljZG4uY29tL2ltZ2V4dHJhL2k0LzI2MzcyNjI4Ni9PMUNOMDF1RlFPUVgxd0oyUEt2cnhOdl8hITI2MzcyNjI4Ni5qcGciPjwvZGl2PjxkaXY+PGltZyBzcmM9Imh0dHBzOi8vaW1nLmFsaWNkbi5jb20vaW1nZXh0cmEvaTEvMjYzNzI2Mjg2L08xQ04wMWxrMWIzdzF3SjJQV05sWTZ1XyEhMjYzNzI2Mjg2LmpwZyI+PC9kaXY+PGRpdj48aW1nIHNyYz0iaHR0cHM6Ly9pbWcuYWxpY2RuLmNvbS9pbWdleHRyYS9pMS8yNjM3MjYyODYvTzFDTjAxdEIzRkNUMXdKMlBVTENDY0RfISEyNjM3MjYyODYuanBnIj48L2Rpdj48ZGl2PjxpbWcgc3JjPSJodHRwczovL2ltZy5hbGljZG4uY29tL2ltZ2V4dHJhL2kyLzI2MzcyNjI4Ni9PMUNOMDF2NVUzOFoxd0oyUFZ3WWpFUl8hITI2MzcyNjI4Ni5qcGciPjwvZGl2PjxkaXY+PGltZyBzcmM9Imh0dHBzOi8vaW1nLmFsaWNkbi5jb20vaW1nZXh0cmEvaTQvMjYzNzI2Mjg2L08xQ04wMUJFanh2TzF3SjJQVUF0b2dLXyEhMjYzNzI2Mjg2LmpwZyI+PC9kaXY+PGRpdj48aW1nIHNyYz0iaHR0cHM6Ly9pbWcuYWxpY2RuLmNvbS9pbWdleHRyYS9pNC8yNjM3MjYyODYvTzFDTjAxaHJjWFNrMXdKMlBYZVI0SkxfISEyNjM3MjYyODYuanBnIj48L2Rpdj48ZGl2PjxpbWcgc3JjPSJodHRwczovL2ltZy5hbGljZG4uY29tL2ltZ2V4dHJhL2kxLzI2MzcyNjI4Ni9PMUNOMDFuTHVVQlExd0oyUGNNYTR0VV8hITI2MzcyNjI4Ni5qcGciPjwvZGl2PjxkaXY+PGltZyBzcmM9Imh0dHBzOi8vaW1nLmFsaWNkbi5jb20vaW1nZXh0cmEvaTMvMjYzNzI2Mjg2L08xQ04wMWRtRVUwMjF3SjJQUGxhMHM1XyEhMjYzNzI2Mjg2LmpwZyI+PC9kaXY+PGRpdj48aW1nIHNyYz0iaHR0cHM6Ly9pbWcuYWxpY2RuLmNvbS9pbWdleHRyYS9pMi8yNjM3MjYyODYvTzFDTjAxV2cwNnVOMXdKMlBSR2htOFpfISEyNjM3MjYyODYuanBnIj48L2Rpdj48ZGl2PjxpbWcgc3JjPSJodHRwczovL2ltZy5hbGljZG4uY29tL2ltZ2V4dHJhL2k0LzI2MzcyNjI4Ni9PMUNOMDFjWm5KNnExd0oyUFZ3Wjg3Ul8hITI2MzcyNjI4Ni5qcGciPjwvZGl2PjxkaXY+PGltZyBzcmM9Imh0dHBzOi8vaW1nLmFsaWNkbi5jb20vaW1nZXh0cmEvaTMvMjYzNzI2Mjg2L08xQ04wMUxvM09lZzF3SjJQY01aWGJwXyEhMjYzNzI2Mjg2LmpwZyI+PC9kaXY+PGRpdj48aW1nIHNyYz0iaHR0cHM6Ly9pbWcuYWxpY2RuLmNvbS9pbWdleHRyYS9pMi8yNjM3MjYyODYvTzFDTjAxYnpzUDNQMXdKMlBSR2dSMjFfISEyNjM3MjYyODYuanBnIj48L2Rpdj48ZGl2PjxpbWcgc3JjPSJodHRwczovL2ltZy5hbGljZG4uY29tL2ltZ2V4dHJhL2k0LzI2MzcyNjI4Ni9PMUNOMDFwU29HUUkxd0oyUFdOaUdNS18hITI2MzcyNjI4Ni5qcGciPjwvZGl2PjxkaXY+PGltZyBzcmM9Imh0dHBzOi8vaW1nLmFsaWNkbi5jb20vaW1nZXh0cmEvaTMvMjYzNzI2Mjg2L08xQ04wMXp0RFNWZDF3SjJQZDkyd21jXyEhMjYzNzI2Mjg2LmpwZyI+PC9kaXY+PGRpdj48aW1nIHNyYz0iaHR0cHM6Ly9pbWcuYWxpY2RuLmNvbS9pbWdleHRyYS9pMy8yNjM3MjYyODYvTzFDTjAxbEZtNjlXMXdKMlBWd1pyclRfISEyNjM3MjYyODYuanBnIj48L2Rpdj48ZGl2PjxpbWcgc3JjPSJodHRwczovL2ltZy5hbGljZG4uY29tL2ltZ2V4dHJhL2kyLzI2MzcyNjI4Ni9PMUNOMDEyOUZqRVAxd0oyUFJHaFZYc18hITI2MzcyNjI4Ni5qcGciPjwvZGl2PjxkaXY+PGltZyBzcmM9Imh0dHBzOi8vaW1nLmFsaWNkbi5jb20vaW1nZXh0cmEvaTMvMjYzNzI2Mjg2L08xQ04wMUpxcmh6YTF3SjJQYkRSd3U3XyEhMjYzNzI2Mjg2LmpwZyI+PC9kaXY+PGRpdj48aW1nIHNyYz0iaHR0cHM6Ly9pbWcuYWxpY2RuLmNvbS9pbWdleHRyYS9pMS8yNjM3MjYyODYvTzFDTjAxeHI1Sk44MXdKMlBSejh5WkhfISEyNjM3MjYyODYuanBnIj48L2Rpdj48ZGl2PjxpbWcgc3JjPSJodHRwczovL2ltZy5hbGljZG4uY29tL2ltZ2V4dHJhL2k0LzI2MzcyNjI4Ni9PMUNOMDFZblVxcTcxd0oyUEt2dUl4Z18hITI2MzcyNjI4Ni5qcGciPjwvZGl2PjxkaXY+PGltZyBzcmM9Imh0dHBzOi8vaW1nLmFsaWNkbi5jb20vaW1nZXh0cmEvaTIvMjYzNzI2Mjg2L08xQ04wMWdHNERpaDF3SjJQWGVTd2prXyEhMjYzNzI2Mjg2LmpwZyI+PC9kaXY+PGRpdj48aW1nIHNyYz0iaHR0cHM6Ly9pbWcuYWxpY2RuLmNvbS9pbWdleHRyYS9pNC8yNjM3MjYyODYvTzFDTjAxRkN4aGc4MXdKMlBVQXNQS1NfISEyNjM3MjYyODYuanBnIj48L2Rpdj48ZGl2PjxpbWcgc3JjPSJodHRwczovL2ltZy5hbGljZG4uY29tL2ltZ2V4dHJhL2k0LzI2MzcyNjI4Ni9PMUNOMDFyTmxiZnkxd0oyUFVBdWNZVV8hITI2MzcyNjI4Ni5qcGciPjwvZGl2PjxkaXY+PGltZyBzcmM9Imh0dHBzOi8vaW1nLmFsaWNkbi5jb20vaW1nZXh0cmEvaTEvMjYzNzI2Mjg2L08xQ04wMTB3NVhKNTF3SjJQVUxEOG5NXyEhMjYzNzI2Mjg2LmpwZyI+PC9kaXY+
Продавец:能梁数码官方旗舰店
Рейтинг:

Всего отзывов:0
Положительных:0
Выберите вариацию / цвет
Добавить в корзину
- Информация о товаре
- Фотографии